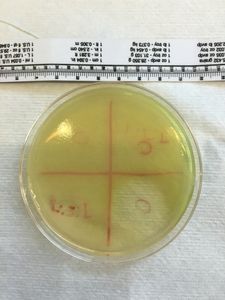

Pseudomonas aeruginosa Biofilm Foldscope Exploration
 Jun 05, 2016 • 8:34 AM UTC
Jun 05, 2016 • 8:34 AM UTC Unknown Location
Unknown Location 140x Magnification
140x Magnification Microorganisms
Microorganisms
Leonardo Biral
Learn about the author...
3posts
4comments
1locations

View in Media Gallery
Hi Everyone,
In my first post, I talked a little bit about my microbiology independent research project that I have been working on for several months now. My project’s focus was destroying P. aeruginosa biofilm formations with isolated bacteriophages.
My original method (the one talked about in my first post) was to grow different triple culture combinations of P. aeruginosa , Staphylococcus aureus , and Escherichia coli overnight and then plate them on a P. aeruginosa lawn. When I did this, I observed zones of clearance around the areas where I plated the triple cultures on the lawn. However, when I took samples from those areas, grew them overnight in nutrient broth, centrifuged, filtered, and plated them on a P. aeruginosa lawn, no zones of clearance were formed as shown by the picture below. I only noticed plaques formed on top of the lawn. This is an interesting result in itself as it shows that whatever is occurring with triple cultures is giving the bacteria the ability to successfully establish a colony on the P. aeruginosa lawn whereas if E. coli or S. aureus were placed on a P. aeruginosa lawn by themselves, they would be overrun by the lawn.
This was not enough. I wanted to create a plaqueless zone of clearance on the lawn, which is a clear indicator of a toxin or bacteriophage. I did some research and found an interesting procedure that described how to isolate bacteriophages that target P. aeruginosa from a solid sample. The solid samples I used were soil samples from three different locations in my school’s garden: a plant bed, the compost heap, and a dry soil heap. I took 1.5 grams of a soil type and treated it with SM Buffer. I took about 1.5 mL of the liquid soil/SM Buffer solution and centrifuged it for 10 minutes and filtered the supernatant with a 0.45 micrometer filter. I then took about 1 mL of this solution and mixed it with 8.5 mL of nutrient broth and 0.5 mL of an overnight P. aeruginosa bacterial culture and grew it for 24 hours. After 24 hours, I divided each of these cultures in multiple Eppendorf tubes and centrifuged them. I filtered the supernatant and placed it on a P. aeruginosa lawn and incubated the plate for 24 hours. This process was done for each soil type.
I did this experimental process twice and I got very interesting results both times. The 2nd time I did the experiment, I clearly noticed a plaqueless zone of inhibition in the lower left quadrant where I plated the refined sample from the dry soil, which is an indicator for a bacteriophage or toxin effective against P. aeruginosa as a competing bacteria would establish a colony in the middle of the zone of inhibition. The large zone of clearance in the bottom right corner is the result of a positive control, Ciprofloxacin. Check it out right here.
In my first post, I talked a little bit about my microbiology independent research project that I have been working on for several months now. My project’s focus was destroying P. aeruginosa biofilm formations with isolated bacteriophages.
My original method (the one talked about in my first post) was to grow different triple culture combinations of P. aeruginosa , Staphylococcus aureus , and Escherichia coli overnight and then plate them on a P. aeruginosa lawn. When I did this, I observed zones of clearance around the areas where I plated the triple cultures on the lawn. However, when I took samples from those areas, grew them overnight in nutrient broth, centrifuged, filtered, and plated them on a P. aeruginosa lawn, no zones of clearance were formed as shown by the picture below. I only noticed plaques formed on top of the lawn. This is an interesting result in itself as it shows that whatever is occurring with triple cultures is giving the bacteria the ability to successfully establish a colony on the P. aeruginosa lawn whereas if E. coli or S. aureus were placed on a P. aeruginosa lawn by themselves, they would be overrun by the lawn.
This was not enough. I wanted to create a plaqueless zone of clearance on the lawn, which is a clear indicator of a toxin or bacteriophage. I did some research and found an interesting procedure that described how to isolate bacteriophages that target P. aeruginosa from a solid sample. The solid samples I used were soil samples from three different locations in my school’s garden: a plant bed, the compost heap, and a dry soil heap. I took 1.5 grams of a soil type and treated it with SM Buffer. I took about 1.5 mL of the liquid soil/SM Buffer solution and centrifuged it for 10 minutes and filtered the supernatant with a 0.45 micrometer filter. I then took about 1 mL of this solution and mixed it with 8.5 mL of nutrient broth and 0.5 mL of an overnight P. aeruginosa bacterial culture and grew it for 24 hours. After 24 hours, I divided each of these cultures in multiple Eppendorf tubes and centrifuged them. I filtered the supernatant and placed it on a P. aeruginosa lawn and incubated the plate for 24 hours. This process was done for each soil type.
I did this experimental process twice and I got very interesting results both times. The 2nd time I did the experiment, I clearly noticed a plaqueless zone of inhibition in the lower left quadrant where I plated the refined sample from the dry soil, which is an indicator for a bacteriophage or toxin effective against P. aeruginosa as a competing bacteria would establish a colony in the middle of the zone of inhibition. The large zone of clearance in the bottom right corner is the result of a positive control, Ciprofloxacin. Check it out right here.

In my first post, someone gave me a great suggestion in the comments and said that I should try to observe biofilms with the Foldscope, so now that I have a better idea of how to use the Foldscope, I decided to give it a shot. I took a sample from the area near the zone of clearance formed on the 2nd plate, made a microscope slide with it, and began exploring! I also tried making observations with my school’s microscope and took photos from both explorations. The 1st photo was taken from the school microscope and the 2nd was taken from the Foldscope.


It honestly boggles my mind how a microscope that costs roughly $1 to make provides the observer with a better quality image than a traditional microscope and is more accessible as taking photos and panning around images is significantly easier. On the traditional microscope, you get a clear overall view of the sample, but the Foldscope lets me see that and the smaller details. The small “grains” visible embedded in the purple areas that represent the extracellular biofilm matrix are the P. aeruginosa bacterial cells.
More Foldscope Images
More Foldscope Images



I am really really impressed by how amazing, practical, and minimalistic the Foldscope is. Absolutely amazing!
Thank you everyone,
Leonardo Biral
Thank you everyone,
Leonardo Biral
Sign in to commentNobody has commented yet... Share your thoughts with the author and start the discussion!

 0 Applause
0 Applause 0 Comments
0 Comments